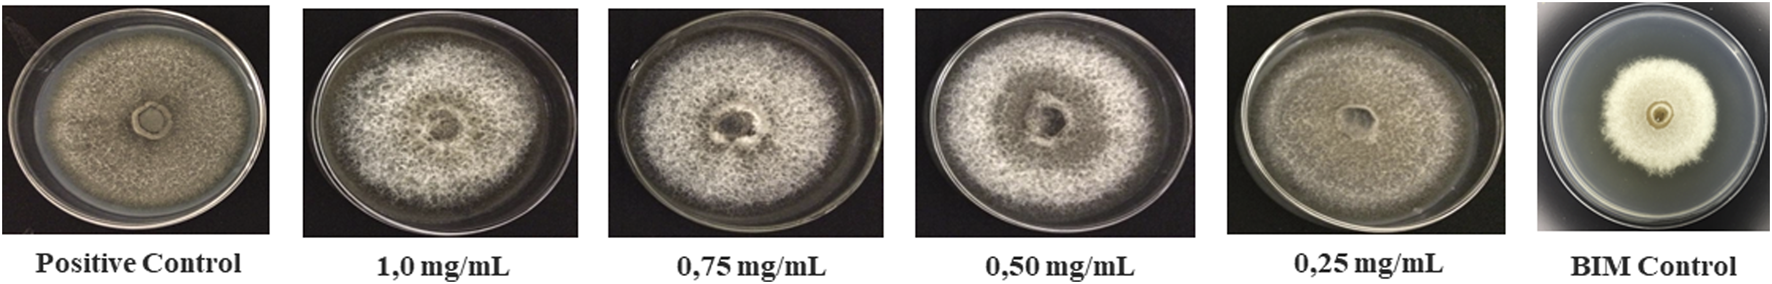

Abstract
Rice blast is a common disease caused by Magnaporthe oryzae which affects rice production worldwide, including Brazil. To reduce the use of harmful pesticides, sustainable control options are necessary for managing rice blast. One possible option is to use plant extracts because they produce secondary metabolites capable of inhibiting the pathogen and controlling the disease. This study aimed to evaluate the potential of ethanolic extracts of leaves and flowers from Banisteriopsis laevifollia, a native Brazilian plant, to antagonise M. oryzae. In vitro antifungal activity assays were carried out, in which mycelium growth reduction, conidia germination, and appressorium formation of M. oryzae were evaluated. In addition, in vivo assay for suppression of leaf blast severity by extracts was done. We also explored the identification of secondary metabolites from ethanolic extracts of leaves and flowers by HPLC–HRMS. Results showed that both leaf and flower extracts inhibited mycelial growth in 21.72% and 30.49%, respectively, due to the inhibition of ergosterol production. Additionally, both extracts inhibited melanin production in the mycelium of M. oryzae by inhibiting tyrosine production. Both leaf and flower extracts significantly inhibited conidia germination and appressorium formation. Furthermore, rice leaves treated with the extracts suppressed by 18.17% and 18.97% leaf blast severity, with the 1.00 mg/mL concentration of flower extract and 0.75 mg/mL concentration of leaf extract, respectively, showing the most significant reduction of leaf blast. The extracts contain phenolic compounds, including 2,3,7,8-tetrahydroxy-chromeno-(5,4,3)-chromene-5,10-dione, 3-(4-hydroxyphenyl)-2-propenoic acid, 2-(3,4-dihydroxyphenyl)-3,4-dihydro-1(2H)-benzopyran-3,5,7-triol, 3,4′,5,7-tetrahydroxyflavone, 3′,4′,5,7-tetrahydroxyflavone, 4′,5,7-trihydroxyflavanone, 3,3′,4′,5,7-pentahydroxyflavone, 3,3′,4′,5,7-pentahydroxyflavone -3-O-glucoside, and 3,3′,4′,5,7-pentahydroxyflavone-3-O-rutinoside, which are likely responsible for the antifungal activity of the extracts. Overall, this study demonstrates the potential of plant extracts as a sustainable alternative for the management of rice blast.
1 Introduction
Rice (Oryza sativa L.) is one of the most important cereal crops produced in Brazil. It is a standout crop due to its strategic role in economics, social, and cultural Brazilian issues (Vinci et al., 2023). With the increase in production, rice blast has emerged as a severe threat to crop management (Sousa et al., 2021), and it is considered the most destructive disease of rice crops (Ning et al., 2020) caused by the pathogen Magnaporthe oryzae B. Couch (asexual morph Pyricularia oryzae) (Wilson and li, 2009). Magnaporthe oryzae can infect rice plants at various growth stages causing significant yield losses ranging from 10% to 100% worldwide (Filippi and Prabhu, 2001; Li et al., 2019).
Rice blast management is fundamental to its sustainable control. In recent years, chemical control has been identified as a principal way of effectiveness and low cost against rice blast (Zhang et al., 2022). However, overuse of chemical control triggers pathogen resistance, bioaccumulation, environmental pollution, and cancer (Bezerra et al., 2021; Persuad et al., 2021). Thus, eco-friendly alternatives, such as plant molecules, have attracted attention because of their non-residual and low-resistance effects (Yanping et al., 2023). Hence, plants used in folk knowledge are great options for researching new molecules capable of controlling blast.
The genus Banisteriopsis is part of the Malpighiaceae family and comprises 92 species that present pantropical distribution (Alexandre et al., 2022). Chemical and biological studies have focused on the potential of Banisteriopsis genus, revealing the presence of various classes of secondary metabolites, such as β-carboline alkaloids (Frias et al., 2012), flavonoids, anthraquinones (Freitas et al., 2015), phenanthrenes (Nunes et al., 2016) and diterpenoids (Alexandre et al., 2022).
Ethnobotanical studies in traditional communities have highlighted the folk use of Banisteriopis laevifolia, popularly known as “cipó-prata” (“silver liane”—lit. Translation into English), for the treatment of ovarian haemorrhage and nephritis, as a topical antimycotic, and to avoid plagues in some crops (Freitas et al., 2015; Nunes et al., 2016). Research studies related to the biological potential of B. laevifolia have reported the antioxidant activity of extracts of leaves and flowers (Alexandre et al., 2022). In addition, the essential oil extracted from the leaves of B. laevifolia showed antifungal activity against yeasts of the genus Candida (Nunes et al., 2016) and antimicrobial potential related to some types of periodontitis, such as Fusobacterium nucleatum, Bacteroides thetaiotaomicron and Porphyronomas gingivalis (Nunes et al., 2016).
Through chemical investigation of the leaves and roots extracts from B. laevifolia has described the presence of 1,3,4,5-tetrahydroxycyclohexane-1-carboxylic acid; 3,3′,4′,5,7-pentahydroxyflavone-3-O-rutinoside; 3,3′,4′,5,7-pentahydroxyflavone-3-O-α-rhamnopyranoside; 3,3′,4′,5,7-pentahydroxyflavone-3-O-glucosilate, 2-(3,4-dihydroxyphenyl)-3,4-dihydro-2H-chromene-3,5,7-triol; 2,2′-bis(3,4-dihydroxyphenyl)-3,3′,4,4′-tetrahydro-2H,2′H-[4,8′-bi-1-benzopyran]-3,3′,5,5′,7,7′-hexol B1 and 2,2′-bis(3,4-dihydroxyphenyl)-3,3′,4,4′-tetrahydro-2H,2′H-[4,8′-bi-1-benzopyran]-3,3′,5,5′,7,7′-hexol B2 (Nunes et al., 2016). Presence of flavonoids 5,7-dihydroxy-2-(4-hydroxyphenyl)-2,3-dihydrochromen-4-one; 3,5,7-trihydroxy-2-(4-hydroxyphenyl)-chromen-4-one; and 3′,4′,5,7-tetrahydroxyflavone, as well as 2,3,7,8-tetrahydroxychromeno (5,4,3)chromene-5,10-dione, 4-hydroxycinnamic acid and 3,4,5-trihydroxybenzoic acid have been described in the flower’s extracts (Alexandre et al., 2022). Thus, due to the activity mentioned for B. laevifolia the analysis of the antagonism against M. oryzae contributes to evaluation of substances that have the potential to be used as eco-friendly control.
In this way, we aimed to provide detailed information about the antifungal properties of B. laevifolia extracts against the pathogen M. oryzae. Thus, this investigation presents findings on the in vitro antagonistic interaction, as well as the in vivo suppression of leaf blast in rice by ethanolic extracts of leaves (EEL) and ethanolic extracts of flowers (EEF) from B. laevifolia.
2 Materials and methods
2.1 Plant material and extraction procedure
Banisteriopsis laevifolia leaves and flowers were previously collected in Goiânia city, Goiás—Brazil and identified by Dr. Aristônio Magalhães Teles from the Universidade Federal de Goiás. According to the extraction procedure done by Alexandre et al. (2022), the extracts of flowers (EEF) (49.7 g, 8.0%) and leaves (EEL) (79.2 g, 11.0%) were obtained.
2.2 HPLC–ESI–HRMS data acquisition
For the identification of B. laevifolia secondary metabolites, each extract (1.0 mg) was dissolved in 1.0 mL of methanol and filtered through a polyester membrane filter (0.45 µm). The chromatographic separation was carried out using a C18 column (Agilent®, 4.6 mm × 100 mm, 3.0 µm), a mobile phase of deionised water (phase A) and methanol (phase B), both acidified with 0.1% formic acid (v/v). The applied gradient was 93:07 (A:B%, v/v), 70:30 (A:B%, v/v) for 10 min, 50:50 (A:B%, v/v) for 5 min, 30:70 (A:B%, v/v) for 3 min, 20:80 (A:B%, v/v) for 2 min, 100 (B%) for 3 min and was maintained for 7 min. The running time was 30 min with a flow rate of 0.3 mL/min, injection volume of 10 μL, and the column temperature was maintained at 20°C.
The HPLC–ESI–HRMS/MS system consisted of an Ultimate 3000 HPLC coupled to a Q-Exactive Orbitrap high-resolution mass spectrometer with heated electrospray ionisation (H–ESI), operated in the negative mode. The MS parameters used were as follows: a spray voltage 3.5 kV, a sheath gas flow rate of 30 arbitrary units, an auxiliary gas flow rate of 10 arbitrary units, a capillary temperature 350°C, an auxiliary gas heater temperature of 250°C, a tube S-lens of 55, an energy of 20 eV, and a data dependent acquisition (DDA) methodology with a mass range (m/z) from 150 to 750. Compound monitoring of compounds was carried out using high-resolution full scan (HRFS) and fragmentation studies were conducted using parallel reaction monitoring (PRM) experiments.
2.3 Standards compounds
Standard compounds 5,7,3′,4′-tetrahydroxyflavan-3-ol (≥96%); 3,3′,4′,5,7-pentahydroxyflavone-3-O-rutinoside (≥98%); 3,3′4′,5,7-pentahydroxyflavone (≥95%); 3,3′4′,5,7-pentahydroxyflavone-3-O-β-glucoside (≥95%); 4′,5,7-trihydroxyflavanone (≥95%); 3-hydroxyphenyl-2-propanoic acid (≥98%); 3′,4′,5,7-tetrahydroxyflavone (≥98%); 3,4′,5,7-tetrahydroxyflavone (≥97%); 2,3,7,8-tetrahydroxy-chromeno-(5,4,3)-chromene-5,10-dione (≥95%) purchased from Sigma-Aldrich (St. Louis, MO, United States).
2.4 Microorganism
The isolate (BRM 31295) was obtained from leaf lesions of the cultivar BRS Primavera, according to the isolated and selected by D’avila et al. (2022). Magnaporthe oryzae isolation for selection of microorganisms was carried out from collections of rice leaves with symptoms of rice blast in areas of rice cultivation in irrigated and upland systems in Brazil, identified morphologically and molecularly. Magnaporthe oryzae isolates were maintained on sterilized filter paper disks in freezer at −20 °C in Multifunctional Collection of Microorganisms from Embrapa Arroz e Feijão.
2.5 Effect of B. laevifolia extracts on in vitro growth of M. oryzae
The bioassay was conducted in a completely randomised design with six treatments: four concentrations of EEL and EEF (0.25, 0.50, 0.75, and 1.0 mg/mL), a positive control consisting of pathogens cultured on potato-dextrose-agar (PDA) in the absence of EEL and EEF, and a negative control consisting of pathogens cultured with dimethyl sulfoxide (DMSO). Previously tests were carried out with DMSO (80, 150, and 200 μL) to evaluate the sensitivity against M. oryzae mycelial. It was noticed only 80 μL of DMSO did not interfere in the development of M. oryzae.
Magnaporthe oryzae isolate was grown for 7 days in Petri dishes containing PDA. After this, extract concentrations were prepared and incorporated into the PDA medium, and the mixture was transferred to Petri dishes. Next, a 9 mm mycelial disc of the pathogen was transferred to the centre of each plate. The treatments were incubated in a Bio-Oxygen Demand (BOD) chamber at 27°C for 9 days under a 12/12 h (light/dark) photoperiod. When the control colony reached the edge of its dish, the diameters of M. oryzae colonies in both assays were measured using a digital pachymeter in a laminar flow chamber at 27°C under continuous white light. The colony area and the amount of reduction were calculated according to Carvalho et al. (2015).
2.6 Conidial germination and appressorium formation of M. oryzae
EEF and EEL were diluted in H2O/DMSO (1:1 v/v) to obtain three suspensions at concentrations of 0.5, 0.75, and 1.0 mg/mL. The isolate was grown for 7 days in Petri dishes with PDA and then transferred to dextrose agar. For colony growth, dishes were kept under continuous white light at 25°C for 7 days. The colonies were then induced to produce conidia according to Prabhu and Filippi (2001). The resulting conidial suspension was filtered and adjusted to 1 × 105 conidia/mL.
Assays were conducted in a completely randomised design with four treatments and three replicates and organised into microscopic slides in Petri dishes previously lined with paper towels moistened with sterile water to provide a high-humidity environment. A 10 μL aliquot of each treatment was separately placed on the hydrophobic side of each previously sterilised piece of parafilm; next, the aliquots and 10 μL of M. oryzae conidial suspension were mixed. Conidial germination and appressorium formation were evaluated after 3, 6 and 24 h by observing the slides under a light microscope (BelAnalyzer MicroImage software was also used). The control consisted of 20 μL of the M. oryzae conidial suspension placed on the same type of support under the same conditions as described above, but mixed with water (Carvalho et al., 2015).
2.7 Leaf blast severity
The test was carried out in a greenhouse at Embrapa Arroz e Feijão - Santo Antônio de Goiás. Planting was carried out in plastic trays (15 cm × 30 cm × 10 cm) containing 3 kg of fertilised soil [5 g of NPK (5-30-15)] and 3 g of ammonium sulphate per 3 kg of soil. The cultivar used was BRS Primavera. The plants were top-dressed 18 days after planting with 3 g of ammonium sulphate. At 21 days after planting, the plants (stage V3) were transferred to plastic cages for inoculation and sprayed with 30 mL of conidia suspension containing different doses of B. laevifolia extract. The plants were challenged with isolate of M. oryzae, at an initial concentration of 6 × 10−5 conidia/mL, and a final concentration of 3 × 10−5 conidia/mL The trial was carried out in a completely randomised design with six treatments and three replications (T1 - control; T2 - fungicide (Bim® 750 g/kg tricyclazole - 250 g/L per hectare + suspension of M. oryzae; T3 - 0.75 mg/mL leaves extract + M. oryzae suspension; T4 - 1.00 mg/mL leaves extract + M. oryzae suspension; T5 - 0.75 mg/mL flowers extract + M. oryzae suspension; T6 - 1.00 mg/mL flowers extract + M. oryzae suspension). Leaf blast severity (%) was determined at 3, 5 and 7 days after inoculation, using the area under the disease progress curve (AUDPC), pathogen latent period (h) and sporulation intensity – IS (conidia/mL) (Bezerra et al., 2021).
2.8 Statistical analysis
The measurements were performed in triplicate. Data was evaluated for normal distribution using the Shapiro-Wilk test, while statistical significance of the samples was carried out using one-way analysis of variance (ANOVA). The means were compared by post hoc Tukey test (p < 0.05). The leaf blast severity data were transformed (√x + 0.5).
3 Results
3.1 Identification of secondary metabolites from B. laevifolia
HPLC–HRMS analysis of EEL and EEF from B. laevifolia identified the chemical structures of several flavonoids and phenolic acids, such as, 3,4,5-trihydroxybenzoic acid, 3,3′,4′,5,7-pentahydroxyflavone, 3,3′,4′,5,7-pentahydroxyflavone-3-O-glucoside, 3,3′,4′,5,7-pentahydroxyflavone-3-O-rutinoside, 5,7,3′,4′-tetrahydroxyflavan-3-ol, and 4′,5,7-trihydroxyflavanone. Additionally, 3-(4-hydroxyphenyl)-2-propenoic acid and 2,3,7,8-tetrahydroxy-chromeno-(5,4,3)-chromene-5,10-dione were observed, as well as the flavonoids 3,4′,5,7-tetrahydroxyflavone and 3′,4′,5,7-tetrahydroxyflavone in the EEF (Table 1).
TABLE 1
| Standard | Sample | ||||||
|---|---|---|---|---|---|---|---|
| Compound | RT (time) | m/z measured | Mass Error (ppm) | Molecular formula | m/z theoretical | RT (time) | |
| 3,4,5-trihydroxybenzoic acid | 17.31 | 169.0130 | 1.01 | C7H6O5 | 169.0215 | 17.29 | EEF and EEL |
| 5,7,3′,4′-tetrahydroxyflavan-3-ol | 20.21 | 289.0712 | 3.30 | C15H14O6 | 289.0726 | 20.22 | EEF and EEL |
| 3,3′,4′,5,7-pentahydroxyflavone-3-O-rutinoside | 25.58 | 609.1470 | 2.74 | C27H30O16 | 609.1456 | 25.59 | EEF and EEL |
| 3,3′,4′,5,7-pentahydroxyflavone -3-O-β-glucoside | 25.70 | 463.0890 | 2.42 | C21H20O12 | 463.0876 | 25.69 | EEF and EEL |
| 2,3,7,8-tetrahydroxy-chromeno-(5,4,3)chromene-5,10-dione | 26.51 | 300.9912 | 3.27 | C14H6O8 | 300.9985 | 26.49 | EEL |
| 3,3′,4′,5,7-pentahydroxyflavone | 27.84 | 301.0358 | 3.70 | C15H10O7 | 301.0336 | 27.83 | EEF and EEL |
| 4′,5,7-trihydroxyflavanone | 28.14 | 271.0616 | 3.16 | C15H12O5 | 271.0607 | 28.14 | EEF and ELL |
| 3-(4-hydroxyphenyl)-2-propenoic acid | 25.18 | 163.0394 | 1.99 | C9H8O3 | 163.0295 | 25.20 | EEF |
| 3′,4′,5,7-tetrahydroxyflavone | 28.36 | 285.0399 | 3.35 | C15H10O6 | 285.0399 | 28.31 | EEF |
| 3,4′,5,7-tetrahydroxyflavone | 28.99 | 285.0409 | 2.92 | C15H10O6 | 285.0399 | 28.99 | EEF |
Phenolic compounds annotated at flowers and leaves extracts of Banisteriopsis laevifolia.
Phenolic compound identification was confirmed by standard compounds (Sigma-Aldrich, St. Louis, MO, United States) and analysed under identical experimental HPLC–HRMS/MS conditions. The precursor mass retention time and main fragment were compared for confirmation. All annotation was confirmed using two independent and orthogonal data, being classified as identified metabolites (Level 1 in MSI level annotation – Sumner et al., 2007).
3.2 In vitro effects inhibition of M. oryzae by B. laevifolia extracts
Inhibition in the growth of the colony of M. oryzae was observed in the presence of both B. laevifolia extracts, noting that the mycelial diameter of the colony was reduced with the increase in extract concentration. Treatments of 1.0 mg/mL of EEL and EEF presented the greatest level of inhibition by 21.72% and 30.49%, respectively (Table 2).
TABLE 2
| Sample | Concentration in mg/mL | ||||
|---|---|---|---|---|---|
| Positive control (A) | 0.25 | 0.50 | 0.75 | 1.0 | |
| Flowers extract | 0.0 | 2.45A | 9.51B | 12.36B | 21,72C |
| Leaves extract | 0.0 | 5.25B | 9.87BC | 17.37C | 30.49D |
Inhibition of mycelial growth of the Magnaporthe oryzae colony (in %) by the effect of ethanolic extracts of Banisteriopsis laevifolia.
Means followed by the same letters were not significantly different from each other according to Tukey’s test (p < 0.05). Capital letters differ by or in the treatments in the columns.
The pigmentation variation of M. oryzae mycelium was observed, appearing whitish in colour when compared to the mycelium of the positive control. This symptom was noticed during the growth phase in the presence of both extracts, demonstrating the absence of melanin production by the pathogen (Figure 1).
FIGURE 1
Morphological difference in Magnaporthe oryzae colony grown in the presence of the ethanolic extract of leaves and flowers of Banisteriopsis laevifolia.
Magnaporthe oryzae mycelium was subjected to treatments with EEL and EEF. Petri dishes without extracts were used to verify the possible effects caused by antagonism on the pathogen. Mycelial development of M. oryzae was observed, revealing reduced growth compared to the positive control and the absence of melanin during the test (Supplementary Figure S1 – Supplementary Material S1).
3.3 Inhibition of conidia germination and appressorium formation of M. oryzae
Banisteriopsis laevifolia extracts affected M. oryzae conidial germination and appressorium formation at different stages. Treatment 1.0 mg/mL of EEL and EEF showed inhibition of 100% of conidia formation at 4 and 6 h after the assay began, while at 16 h inhibition was measured at 95.8% and 94.2%, respectively. Moreover, all treatments of EEL and EEF inhibited M. oryzae appressorium formation by 100% at 4, 6, and 16 h (Figure 2).
FIGURE 2

(A) Germinated conidia of Magnaporthe oryzae in the presence of ethanolic extract of leaves from Banisteripsis. laevifolia; (B) Germinated conidia of M. oryzae in the presence of ethanolic extract of flowers from B. laevifolia. Means followed by the same letters do not differ according to the Tukey test (p < 0.05).
3.4 Suppression of rice leaf blast by B. laevifolia extracts
Rice leaves inoculated with M. oryzae and treated with EEL and EEF showed a reduction in the leaf blast severity (LBS). Among the treatments, the one with 0.75 mg/mL of EEL at 3 days after inoculation (DAI) showed 0.17% of injured leaf area and the treatment with 1.00 mg/mL of EEF, at 5 and 7 days of evaluation, showed 1.12% and 1.61% of injured leaf area, respectively, as presented in Table 3.
TABLE 3
| Treatments | LBS (%) | AUDPC | ||
|---|---|---|---|---|
| 3 DAI | 5 DAI | 7 DAI | ||
| Control (M. oryzae) | 2.11Ac | 6.24Ab | 31.13Aa | 167.41 |
| Fungicide (Bim®) | 1.22ABc | 2.61Bb | 18.66Ba | 92.12 |
| 0.75 mg/mL (EEL) | 0.17Cc | 1.46Cb | 2.16Da | 18.97 |
| 1.00 mg/mL (EEL) | 1.32ABc | 2.96Ba | 4.43Cb | 45.47 |
| 0.75 mg/mL (EEF) | 1.35Bb | 2.33Bb | 2.57Da | 34.76 |
| 1.00 mg/mL (EEF) | 0.67Cb | 1.12Db | 1.61Ea | 18.17 |
Leaf blast severity (LBS) and area under the disease progress curve (AUDPC) in rice plants treated with ethanolic extracts of leaves (EEL) and flowers (EEF) of Banisteriopsis leavifolia under greenhouse conditions.
Means followed by the same letters were not significantly different from each other according to Tukey’s test (p < 0.05). Capital letters represent the treatments in the columns and lowercase letters represent the evaluation days from each other, in the rows. Leaf blast severity (number of lesions per cm2 of leaf) in 7 days of evaluation.
In terms of area under the disease progress curve (AUDPC), EEF at the concentration of 1.00 mg/mL resulted in a significantly smaller curve area of 18.17 compared to the control group (167.41) (Figure 3). Additionally, the treatment with EEF at 1.00 mg/mL exhibited a longer latent period (LP) of 96 h, in contrast to the control group which showed an LP of 36 h (Figure 4A). Moreover, the sporulation intensity (SI) of the treatment group using EEF at 1.00 mg/mL was found to be 8.56 conidia/mL, while the control group presented a much higher SI of 56.09 conidia/mL (Figure 4B).
FIGURE 3

Area under the disease progress curve for the treatments evaluated (T1 - Control, T2 - Fungicide (Bim ® 750 g/kg Tricyclazole—250 g/L.1/ha + M. oryzae suspension, T3—0.75 mg/mL of leaf extract + M. oryzae suspension, T4—1.00 mg/mL of leaf extract + M. oryzae suspension, T5—0.75 mg/mL of flower extract + M. oryzae suspension, T6—1.00 mg/mL of flower extract + M. oryzae suspension) and lesions developed by the pathogen in each treatment.
FIGURE 4

(A) Latent period (LP) and (B) sporulation intensity (SI) of the pathogen submitted to different treatments (T1 - Control, T2 - Fungicide (Bim ® 750 g/kg Tricyclazole – 250 g/L.1/ha + M. oryzae suspension, T3 – 0.75 mg/mL of leaf extract + M. oryzae suspension, T4 – 1.00 mg/mL of leaf extract + M. oryzae suspension, T5 – 0.75 mg/mL of flower extract + M. oryzae suspension, T6 – 1.00 mg/mL of flower extract + M. oryzae suspension).
4 Discussion
Numerous bioactive metabolites are found in the Banisteriopsis species, with particular emphasis on their abundance of pharmacologically active alkaloids (Frias et al., 2012). However, searches for chemical constituents from EEL and EEF have provided a fresh perspective, demonstrating that the identified compounds are predominantly related to phenolic compounds. Previous studies have described polyphenols in leaves (Nunes et al., 2016), flowers (Alexandre et al., 2022), and roots (Freitas et al., 2015) of Banisteriopsis species.
Concerning the biological activity, flavonoids and phenolic acids have contributed to antioxidant activity and might have a role in antifungal effects (Silva B. et al., 2021), such as the inhibitory action on the germination of spores of pathogens in plants, such as Aspergillus ochracues, Colletotrichum lindemuthianum, Fusarium oxysporum, and Cladosporium shaerospemum (Jin, 2019; Kalid et al., 2019). This class of metabolites might act in fungal structural cells, inducing morphological changes, inhibiting hyphal development, defunctionalisation of pathogen metabolism, and promoting apoptosis (Silva C. R. et al., 2014; Jin, 2019).
Some of the compounds identified in ethanolic extracts of B. laevifolia have demonstrated antifungal activity against certain pathogens. Previous studies describe antifungal action of 4′,5,7-trihydroxyflavanone, 3,3′,4′,5,7-pentahydroxyflavone, and 3,4′,5,7-tetrahydroxyflavone against Aspergillus flavus, reducing mycelial growth and inhibiting aflatoxin production (Tian et al., 2023). In addition, 3,4,5-trihydroxybenzoic acid, 2-(3,4-dihydroxyphenyl)-3,4-dihydro-1(2H)-benzopyran-3,5,7-triol, and 3,3′,4′,5,7-pentahydroxyflavone-3-O-rutinoside were demonstrated inhibition in mycelial growth and spore germination of Colletotrichum spp. (Silva B. et al., 2021).
Sustainable control has been a traditional practice for centuries, but the prosperity of green revolution would lead to an increase in the use of eco-friendly pest control. Nevertheless, with the emergence of fungal pathogens resistant to chemicals, environmental degradation resulting from excessive pesticide application, and the costly nature of chemical fungicides, there is a growing need to explore novel techniques that corroborate with blast management (Chaibub et al., 2020). Thus, the use of plant extracts is one such method that can mitigate fungal pathogen resistance to chemical fungicides while simultaneously minimising environmental damage caused by the unrestricted use of synthetic substances.
To investigate antifungal activity, the mycelial growth of M. oryzae was observed in the presence of EEL and EEF. An antagonistic relationship was noticed between the B. laevifolia extracts and M. oryzae, in which the treatment 1.0 mg/mL of EEF demonstrated the greatest reduction against colonial growth of the pathogen. This may be attributed to the presence of simple phenolic compounds such as 2,3,7,8-tetrahydroxy-chromeno-(5,4,3)-chromene-5,10-dione and 3-(4-hydroxyphenyl)-2-propenoic acid, as well as the flavonoids 3′,4′,5,7-tetrahydroxyflavone and 3,4′,5,7-tetrahydroxyflavone, which were not detected in EEL. Phenolic compounds have the ability to disrupt the biosynthesis of ergosterol, a crucial component in cell permeability regulation, and mycelium development (Redondo-Blanco et al., 2020). When ergosterol availability in the plasma membrane is reduced, cellular components may leak out, disrupting cell replication and compromising hyphae formation (Patel et al., 2020).
In addition, alterations were detected on the mycelium of M. oryzae after 24 h of the assay in the presence of EEL and EEF. A distinctive orange-coloured halo was observed around the mycelium of M. oryzae in all treatments of both B. laevifolia extracts, indicating the production of mycotoxins and inhibitory enzymes by the pathogen (Supplementary Figure S2 – Supplementary Material S1). This observation implies that the pathogen may have released enzymes that are responsible for breaking down the substances present in the substrate. Additionally, it is suggested that there may have been oxidation of metabolic processes by the pathogen, potentially affecting the cell wall of M. oryzae mycelium (Collemare et al., 2008; Patel et al., 2020).
Furthermore, the mycelium of M. oryzae displayed altered pigmentation, manifesting as whitish hues in contrast to the mycelium of the positive control treatment. This change could be attributed to the potential of phenolic compounds to inhibit tyrosinase production (Fan et al., 2019). As a result, the impact of EEL and EEF was comparable to that of tricyclazole, which restrains the biosynthesis of tyrosinase to inhibit M. oryzae growth (Bezerra et al., 2021). Biosynthesis of melanin provides M. oryzae adaptive benefits, which act as a shield against environmental factors, such as UV and ionising radiation, abiotic stress, and serve as a crucial virulence factor (Oliveira et al., 2020). As well, melanin production is vital for appressoria maturation, and its absence results in inadequate turgor pressure needed for the appressorium to penetrate the leaf cuticle of rice (Wilson and li, 2009; Bezerra et al., 2021).
Subsequent tests were carried out without EEL and EEF to explore any potential impacts on the mycelium of M. oryzae following antagonism. The inhibition of mycelial growth was also corroborated by the decrease in melanin. These outcomes provide evidence of the potential fungistatic effect of B. laevifolia extracts, which may facilitate M. oryzae management at a minimal toxic level, without eliminating it from the environment. Furthermore, this approach might help to reduce the incidence of resistance to the compounds present in the extracts.
The impact of EEL and EEF on conidia germination and appressorium formation of M. oryzae was observed, having noted a marked decrease in conidia germination for both Banisteriopsis extracts. Moreover, the formation of appressoria was entirely inhibited by EEL and EEF. These results imply a synergistic effect of the phenolic compounds found in EEL and EEF, which can impede the spore germination of plant pathogens (Jin, 2019; Kalid et al., 2019). Conidial germination and appressorium formation of M. oryzae are crucial stages in the infection cycle. Appressorium formation plays a key role in breaking the leaf cuticle and triggering host invasion through penetration by infective hyphae that invade the epidermal cells of rice (Wilson and li, 2009; Khang and Valent, 2010). Thus, it might be inferred that the outcome observed was caused by a reduction in mucilage production, which is essential for conidia to attach to the leaf cuticle. Consequently, this impedes the signalling required for conidia germination and the subsequent development of appressorium.
Regarding the suppression of rice blast by B. laevifolia extracts, our results demonstrated significant reduction in LBS, highlighting the treatment with 0.75 mg/mL of EEL and 1.00 mg/mL of EEF. This suggests that the extracts might stimulate plant resistance, increasing the activity of enzymes related to plant defence, such as chitinase, β-1,3-glucanase peroxidase, and lipoxygenase (Chaibub et al., 2020). Such induction might have the potential to hinder the various developmental stages of pathogens, such as their ability to penetrate the leaf cuticle and establish colonisation. This effect could be attributed to phenolic compounds, such as 3,3′,4′,5,7-pentahydroxyflavone, 3,3′,4′,5,7-pentahydroxyflavone-3-O-rutinoside, 3′,4′,5,7-tetrahydroxyflavone, 4′,5,7-trihydroxyflavanone, and 2-(3,4-dihydroxyphenyl)-3,4-dihydro-1(2H)-benzopyran-3,5,7-triol (Nag et al., 2022; Tian et al., 2023), which may play a vital role in eliciting the production of phytoalexins in rice plants. These phytoalexins are synthesised in response to attacks by M. oryzae, and their synthesis is due to the increased activity of defence hormones like salicylic acid, which may act, directly or indirectly, with other signalling substances, like jasmonic acid and ethylene, against M. oryzae (Garcia et al., 2017).
Thus, the compounds reported in this work present the potential to develop future biofungicides for the management of leaf blast control. It also can be used to clarify the components of the rice defence signalling pathway.
5 Conclusion
The chemical profile investigation of ethanolic extracts of leaves and flowers from B. laevifolia lead to the identification of eleven phenolic compounds belonging to the sub-classes of flavonoids and phenolic acids. Promising results in biological assays of B. laevifolia extracts against M. oryzae were observed, as EEL and EEF displayed fungistatic activity. This implies the inhibitory potential of 3,3′,4′,5,7-pentahydroxyflavone, 2-(3,4-dihydroxyphenyl)-3,4-dihydro-1(2H)-benzopyran-3,5,7-triol, 4′,5,7-trihydroxyflavanone, 3,3′,4′,5,7-pentahydroxyflavone-3-O-rutinoside, and other flavonoids and phenolic acids present in leaves and flowers, which may present synergistic action in various metabolic pathways of M. oryzae. Given the effects on the mycelium and conidia of M. oryzae, the results warrant future investigation in order to expand knowledge on the use of plant extracts that influence the plant/pathogen interaction, which could be a crucial step toward developing a control of rice blast.
Statements
Data availability statement
The original contributions presented in the study are included in the article/Supplementary Material, further inquiries can be directed to the corresponding author.
Author contributions
JS management and responsible for chemical and in vitro studies, conceptualisation, writing the original manuscript draft and editing; MT was responsible for chemical studies, conceptualisation, writing the original manuscript draft and editing; MS and CC were responsible for in vitro studies and editing; MA and GB were responsible for in vivo studies, conceptualisation and review; MF and LA were responsible for biological studies, conceptualisation of the original manuscript draft and editing; and VP was responsible for investigation, conceptualisation, project administration and management, and writing the original draft. All authors contributed to the article and approved the submitted version.
Funding
We sincerely and gratefully thank the Conselho Nacional de Desenvolvimento Científico e Tecnológico for financial support of this project No. 422513/2016-4.
Conflict of interest
The authors declare that the research was conducted in the absence of any commercial or financial relationships that could be construed as a potential conflict of interest.
Publisher’s note
All claims expressed in this article are solely those of the authors and do not necessarily represent those of their affiliated organizations, or those of the publisher, the editors and the reviewers. Any product that may be evaluated in this article, or claim that may be made by its manufacturer, is not guaranteed or endorsed by the publisher.
Supplementary material
The Supplementary Material for this article can be found online at: https://www.frontiersin.org/articles/10.3389/fntpr.2023.1224617/full#supplementary-material
References
1
Alexandre G. P. Simão J. L. S. Tavares M. O. A. Zuffo I. M. S. Prado S. V. Paiva J. A. et al (2022). Dereplication by HPLC–ESI–MS and antioxidant activity of phenolic compounds from Banisteriopsis laevifolia (Malpighiaceae). An. Acad. Bras. Cienc.94 (1), e20201844. 10.1590/0001-3765202220201844
2
Bezerra G. A. Chaibub A. A. Oliveira M. I. S. Mizubuti E. S. G. Filippi M. C. C. (2021). Evidence of Pyricularia oryzae adaptability to tricyclazole. J. Environ. Sci. Health B.56 (10), 869–876. 10.1080/03601234.2021.1971913
3
Carvalho J. C. B. Sousa K. C. I. Brito D. C. Chaibub A. A. Luzini A. P. Côrtes M. C. V. B. et al (2015). Biocontrol potential of Waitea circinate, an orchid mycorrhizal fungus, against the rice blast fungus. Trop. Plant Pathol.40 (3), 151–159. 10.1007/s40858-015-0042-8
4
Chaibub A. A. Sousa T. P. Oliveira M. I. S. Arriel-Elias M. T. Araújo L. G. Filippi M. C. C. (2020). Efficacy of Cladosporium cladosporioides C24G as a multifunctional agent in upland rice in agroecological systems. Int. J. Plant Prod.14, 463–474. 10.1007/s42106-020-00097-2
5
Collemare J. Billard A. Böhnert H. U. Lebrun M. H. (2008). Biosynthesis of secondary metabolites in the rice blast fungus Magnaporthe grisea: the role of hybrid PKS-NRPS in pathogenicity. Mycol. Res.112 (2), 207–215. 10.1016/j.mycres.2007.08.003
6
D’avila L. S. Filippi M. C. C. Café-Filho A. C. (2022). Fungicide resistance in Pyricularia oryzae populations from southern and northern Brazil and evidence of fitness costs for QoI-resistant isolates. Crop Prot.153, 105887. 10.1016/j.cropro.2021.105887
7
Fan M. Ding H. Zhang G. Hu X. Gong D. (2019). Relationships of dietary flavonoid structure with its tyrosinase inhibitory activity and affinity. LWT107, 25–34. 10.1016/j.lwt.2019.02.076
8
Filippi M. C. Prabhu A. S. (2001). Phenotypic virulence analysis of Pyricularia grisea isolates from Brazilian upland rice cultivars. Pesq. Agropec. Bras.36 (1), 27–35. 10.1590/S0100-204X2001000100004
9
Freitas L. B. O. Boaventura M. A. D. Santos W. L. Stehmann J. R. Junior D. D. Lopes M. T. P. et al (2015). Allelopathic, cytotoxic and antifungic activities of new dihydrophenanthrenes and other constituents of leaves and roots extracts of Banisteriopsis anisandra (Malpighiaceae). Phytochem. Lett.12, 9–16. 10.1016/j.phytol.2015.02.006
10
Frias U. A. Costa M. C. M. Takahashi J. A. Oki Y. (2012). Banisteriopis species: a source of bioactive potential medical application. Int. J. Biotechnol. Wellness Ind.1 (3), 163–171. 10.6000/1927-3037/2012.01.03.02
11
Garcia M. L. Ferreira N. L. O. Arruda R. L. Filippi M. C. C. Conceição E. C. (2017). Standardized rosemary extract induces host plant defenses and suppresses rice leaf blast. J. Med. Plant Res.5 (5), 39–45.
12
Jin Y. S. (2019). Recent advances in natural antifungal flavonoids and their derivatives. Bioorg. Med. Chem. Lett.29 (19), 126589. 10.1016/j.bmcl.2019.07.048
13
Kalid M. Rahman S. Bilal M. Huang D. F. (2019). Role of flavonoids in plant interactions with the environment and against human pathogens — a review. J. Integr. Agric.18 (1), 211–230. 10.1016/S2095-3119(19)62555-4
14
Khang C. H. Valent B. (2010). in Magnaporthe oryzae and rice blast disease” In: cellular and molecular biology filamentous fungi. Editors BorkovichK. A.EbboleD. J. (Washington, DC: ASM Press), 593–606. 10.1128/9781555816636.ch37
15
Li W. Chern M. Yin J. Wang J. Chen X. (2019). Recent advances in broad-spectrum resistance to the rice blast disease. Curr. Opin. Plant Biol.50, 114–120. 10.1016/j.pbi.2019.03.015
16
Nag P. Paul S. Shriti S. Das S. (2022). Defence response in plants and animals against a common fungal pathogen, Fusarium oxysporum. Microbiol. Curr. Res.3, 100135. 10.1016/j.crmicr.2022.100135
17
Ning X. Yunyu W. Aihong L. (2020). Strategy for use of rice blast resistance genes in rice molecular breeding. Rice Sci.27 (4), 263–277. 10.1016/j.rsci.2020.05.003
18
Nunes B. C. Martins M. M. Chang R. Morais S. A. L. Nascimento E. A. Oliveira A. et al (2016). Antimicrobial activity, cytotoxicity and selectivity index of Banisteriopsis laevifolia (a. Juss) B. Gates leaves. Ind. Crops Prod.92, 277–289. 10.1016/j.indcrop.2016.08.016
19
Oliveira L. Ferrarini M. Santos A. P. Varela M. T. Corrêa I. T. S. Tempone A. G. et al (2020). Coumaric acid analogues inhibit growth and melanin biosynthesis in Cryptococcus neoformans and potentialize amphotericin B antifungal activity. Eur. J. Pharm. Sci.153, 105473. 10.1016/j.ejps.2020.105473
20
Patel M. Srivastava V. Ahmad A. (2020). Dodonaea viscosa var. angustifolia derived 5,6,8-trihydroxy-7,4’ dimethoxy flavone inhibits ergosterol synthesis and the production of hyphae and biofilm in Candida albicans. J. Ethnopharmacol.259, 112965. 10.1016/j.jep.2020.112965
21
Persuad R. Saravanakumar D. Persuad M. Seepersad G. (2021). Biological and new generation fungicides in the management of Blast Disease in rice. Front. Sustain. Food Syst.5, 797441. 10.3389/fsufs.2021.797441
22
Prabhu A. S. Filippi M. C. (2001). Graus de resistência à brusone e produtividade de cultivares melhoradas de arroz de terras altas. Pesq. Agropec. Bras.36 (12), 1453–1459. 10.1590/S0100-204X2001001200002
23
Redondo-Blanco S. Fenández J. López-Ibañez S. Miguélez E. M. Villar C. J. Lombó F. (2020). Plant phytochemicals in food preservation: antifungal bioactivity: a review. J. Food Prot.83 (1), 163–171. 10.4315/0362-028X.JFP-19-163
24
Silva B. Biluca F. C. Gonzaga L. V. Fett R. Dalmarco E. M. Caon T. et al (2021). In vitro anti-inflammatory properties of honey flavonoids: a review. Food Res. Int.141, 110086. 10.1016/j.foodres.2020.110086
25
Silva C. R. Andrade Neto J. B. Campos R. S. Figueiredo N. S. Sampaio L. S. Magalhães H. I. F. et al (2014). Synergic effect of the flavonoids catechin, quercetin or epigallocatechin gallate with fluconazole induces apoptosis in Candida tropicalis resistant to fluconazole. Antimicrob. Agents Chemother.58 (3), 1468–1478. 10.1128/AAC.00651-13
26
Sousa R. O. Carlos F. S. Silva L. S. Scivittaro W. B. Ribeiro P. L. Lima C. L. R. (2021). No-tillage for flooded rice in Brazilian subtropical paddy fields: history, challenges, advances and perspectives. Rev. Bras. Cien. Solo.45, e0210102. 10.36783/18069657rbcs20210102
27
Sumner L. W. Amberg A. Barrett D. Beale M. H. Beger R. Daykin C. A. et al (2007). Proposed minimum reporting standards for chemical analysis Chemical Analysis Working Group (CAWG) metabolomics standards initiative (MSI). Metabolomics3 (3), 211–221. 10.1007/s11306-007-0082-2
28
Tian F. Woo S. Y. Lee S. Y. Park S. B. Im J. H. Chun H. S. (2023). Plant-based natural flavonoids show strong inhibition of aflatoxin production and related gene expressions correlated with chemical structure. Food. Microb.109, 104141. 10.1016/j.fm.2022.104141
29
Vinci G. Ruggieri R. Ruggieri M. Prencipe S. A. (2023). Rice production chain: environmental and social impact assessment—a review. Agriculture13 (2), 340. 10.3390/agriculture13020340
30
Wilson R. A. li N. J. (2009). Under pressure: investigating the biology of plant infection by Magnaporthe oryzae. Nat. Rev. Microbiol.7 (3), 185–195. 10.1038/nrmicro2032
31
Yanping T. Shigi D. Yonghua Q. Xin X. You Y. Liu C. et al (2023). Evaluation of medicinal plant extracts for Rice Blast Disease control. Rice Sci.30 (1), 6–10. 10.1016/j.rsci.2022.03.003
32
Zhang H. F. Islam T. Liu W. D. (2022). Integrated pest management programme for cereal blast fungus Magnaporthe oryzae. J. Integr. Agric.21 (12), 3420–3433. 10.1016/j.jia.2022.08.056
Summary
Keywords
Banisteriopsis genus, Magnaporthe oryzae , rice blast disease, eco-friendly control, phenolic compound, conidia germination rate
Citation
Simão JLS, Teodorico MSdS, Silva MIdSC, Coelho CTP, Bezerra GdA, Arriel Elias MT, de Fillipi MCC, de Araújo LG and Pasqualotto Severino VG (2023) Evidence of antagonism in vitro and in vivo of extracts from Banisteriopsis laevifolia (A. Juss) B. Gates against the rice blast fungus. Front. Nat. Produc. 2:1224617. doi: 10.3389/fntpr.2023.1224617
Received
17 May 2023
Accepted
11 October 2023
Published
02 November 2023
Volume
2 - 2023
Edited by
Christopher S. Jeffrey, University of Nevada, Reno, United States
Reviewed by
Adriana Lopes, University of Ribeirão Preto, Brazil
Marcos Soto Hernandez, Colegio de Postgraduados (COLPOS), Mexico
Ana Mutis, University of La Frontera, Chile
Updates
Copyright
© 2023 Simão, Teodorico, Silva, Coelho, Bezerra, Arriel Elias, de Fillipi, de Araújo and Pasqualotto Severino.
This is an open-access article distributed under the terms of the Creative Commons Attribution License (CC BY). The use, distribution or reproduction in other forums is permitted, provided the original author(s) and the copyright owner(s) are credited and that the original publication in this journal is cited, in accordance with accepted academic practice. No use, distribution or reproduction is permitted which does not comply with these terms.
*Correspondence: Jorge Luiz Souza Simão, jorgesimao@discente.ufg.br; Vanessa Gisele Pasqualotto Severino, vanessapasqualotto@ufg.br
Disclaimer
All claims expressed in this article are solely those of the authors and do not necessarily represent those of their affiliated organizations, or those of the publisher, the editors and the reviewers. Any product that may be evaluated in this article or claim that may be made by its manufacturer is not guaranteed or endorsed by the publisher.